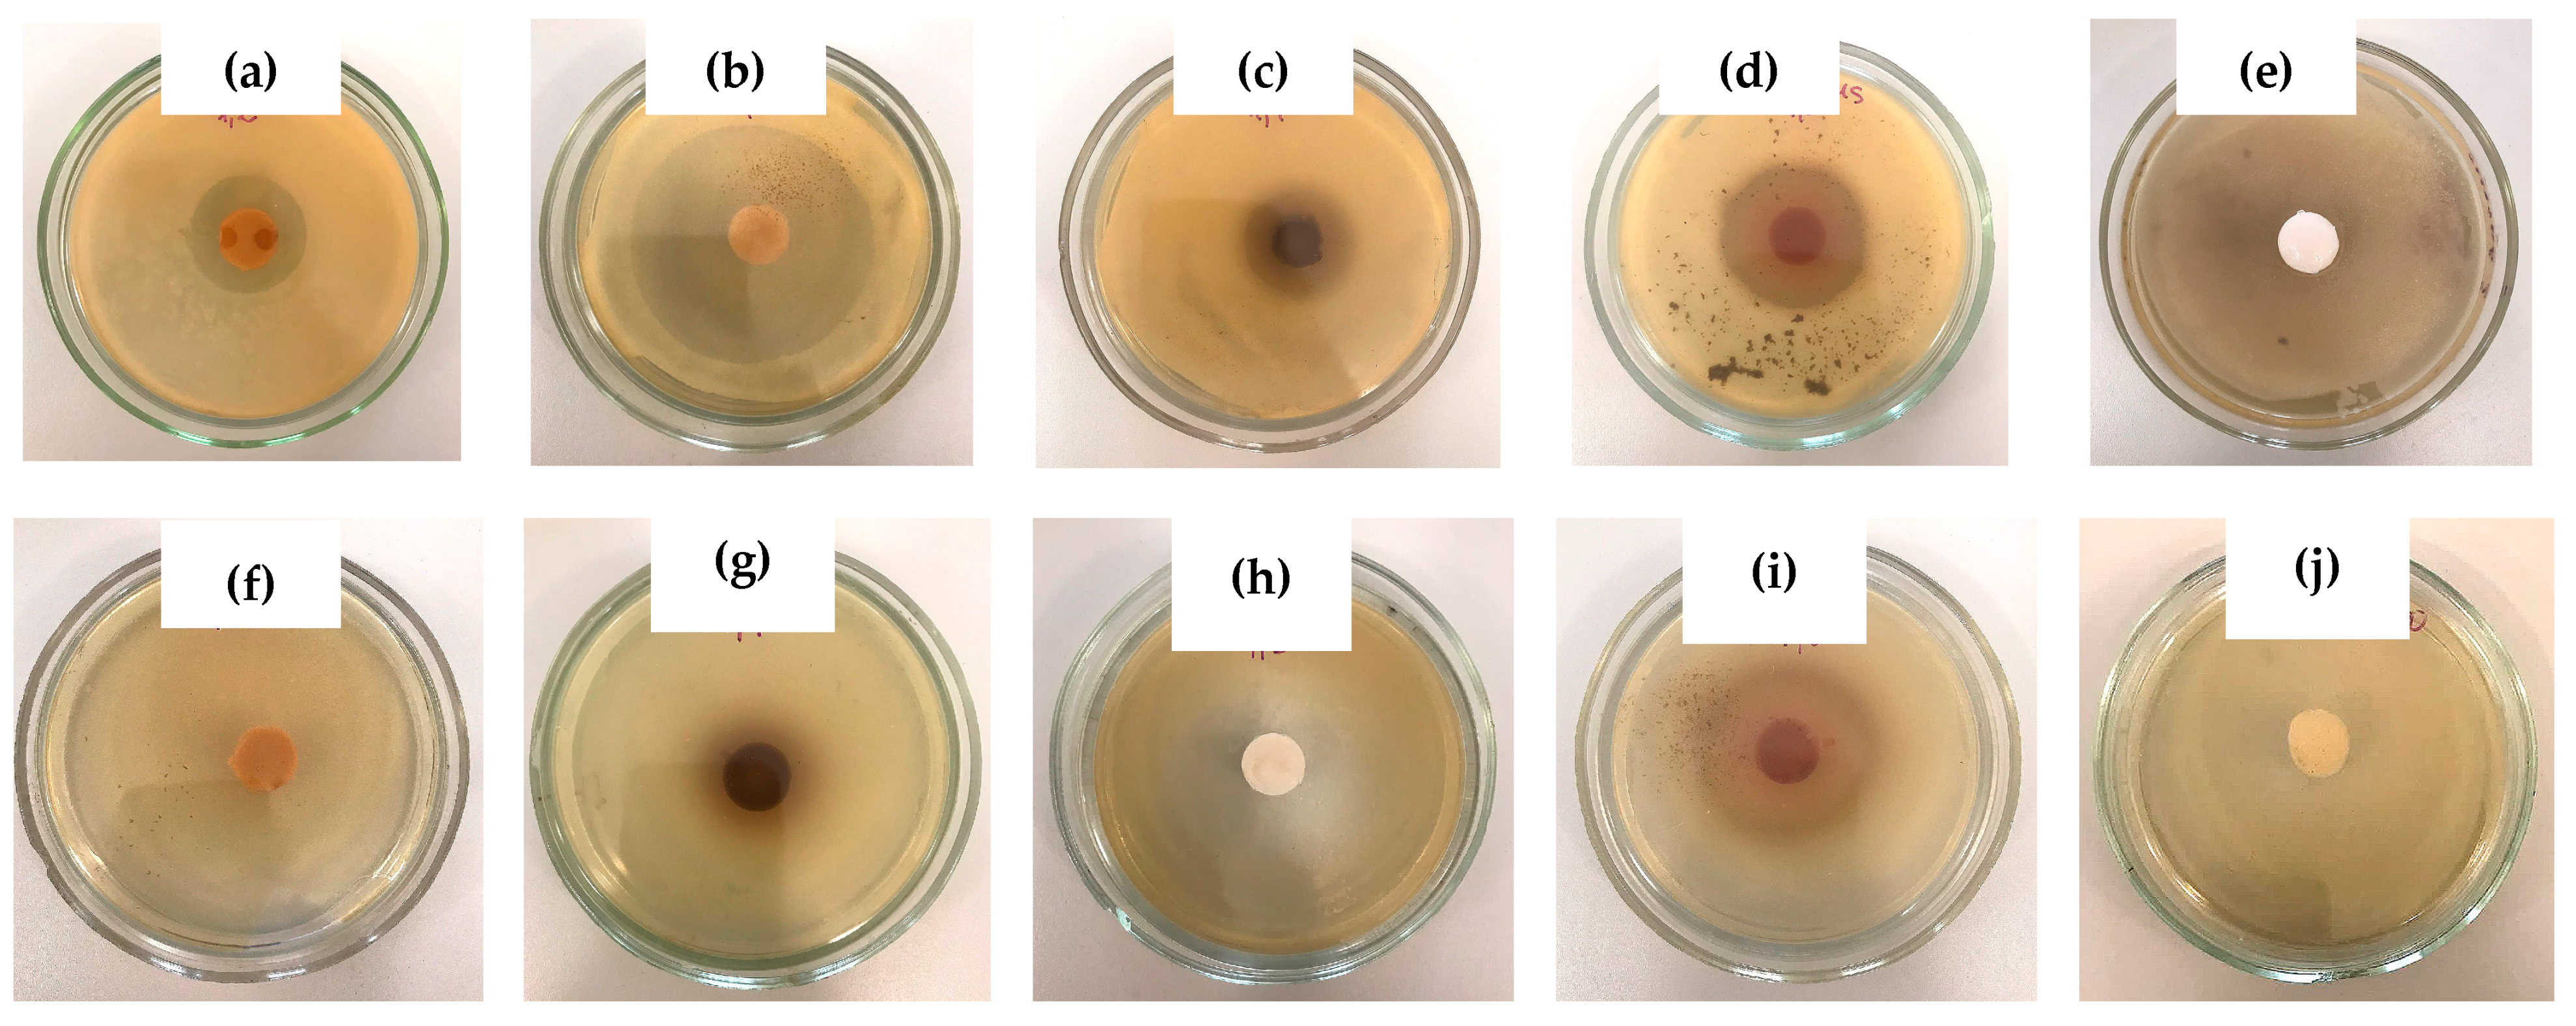
Polymers 16 00675 g008

Cryostructuring of Polymeric Systems: 67 Properties and Microstructure of Poly(Vinyl Alcohol) Cryogels Formed in the Presence of Phenol or Bis-Phenols Introduced into the Aqueous Polymeric Solutions Prior to Their Freeze–Thaw Processing †
Abstract
:1. Introduction
2. Results and Discussion
2.1. Influence of Phenolic Additives on Rheological Properties of Aqueous PVA Solutions Used for the Preparation of PVACGs
2.2. Preparation and Physico-Chemical Properties of the Additive-Free and Phenolic-Additive-Containing PVA Cryogels
2.3. Changes in the Physico-Chemical Properties of PVA Cryogels as a Result of the Transformation of “Primary” PVACGs into “Secondary” Ones
2.4. Microstructure of the “Secondary” PVA Cryogels
2.5. Peculiarities of Phenolic Substance Release from the Additive-Containing “Primary” PVA Cryogels
3. Conclusions
4. Materials and Methods
4.1. Chemicals
4.2. Methods
4.2.1. Preparation of the Initial PVA and PVA/Phenol Solutions
4.2.2. Viscosimetry Studies of the Additive-Free and Additive-Containing PVA Solutions
4.2.3. Preparation of the Additive-Free and Additive-Containing PVA Cryogels
4.2.4. Physico-Mechanical Characteristics of the Additive-Free and Additive-Containing PVA Cryogels
4.2.5. Fusion Temperatures of the Additive-Free and Additive-Containing PVA Cryogels
4.2.6. Microstructure of PVA Cryogels Formed in the Absence and in the Presence of Phenolic Additives
4.2.7. Release of Phenolic Additives from the Additive-Containing PVA Cryogels
4.2.8. In Vitro Evaluation of Antibacterial Activity of PVA Cryogels Carrying Additives of Phenol and Bis-Phenols
Author Contributions
Funding
Institutional Review Board Statement
Informed Consent Statement
Data Availability Statement
Acknowledgments
Conflicts of Interest
References
- Kukharchik, M.M.; Baramboim, N.K. Variation of the properties of poly(vinyl alcohol) aqueous solutions under cryogenic influence. Vysokomol. Soedin 1972, 14, 843–846. (In Russian) [Google Scholar]
- Inoue, T. Gelled Vinyl Alcohol Polymers and Articles Therefrom. US Patent 3,875,303, 1 April 1975. [Google Scholar]
- Peppas, N.A. Turbidimetric studies of aqueous poly(vinyl alcohol) solutions. Makromol. Chem. 1975, 176, 3433–3440. [Google Scholar] [CrossRef]
- Lozinsky, V.I. Cryotropic gelation of poly(vinyl alcohol). Russ. Chem. Rev. 1998, 67, 573–586. [Google Scholar] [CrossRef]
- Hassan, C.M.; Peppas, N.A. Structure and applications of poly(vinyl alcohol) hydrogels produced by conventional crosslinking or by freezing/thawing methods. Adv. Polym. Sci. 2000, 153, 37–65. [Google Scholar] [CrossRef]
- De Rosa, C.; Auriemma, F.; Di Girolamo, R. Kinetic analysis of cryotropic gelation f poly(vinyl alcohol)/water solutions by small-angle neutron scattering. Adv. Polym. Sci. 2014, 263, 159–197. [Google Scholar] [CrossRef]
- Nambu, M.; Tatsuo, K.; Watase, M. Process for Increasing the Mechanical Strength of a Frozen Gel of Polyvinyl Alcohol. European Patents 0,107,055, 24 September 1982. [Google Scholar]
- Watase, M.; Nishinari, K.; Nambu, M. Anomalous increase in the elastic modulus of frozen poly(vinyl alcohol) gels. Cryo-Letters 1983, 4, 197–200. [Google Scholar]
- Watase, M.; Nishinari, K.; Nambu, M. Rheological properties of an anomalous poly(vinyl alcohol) gel. Polym. Commun. 1983, 24, 52–54. [Google Scholar]
- Hatakeyama, T.; Yamaguchi, A.; Hatakeyama, H. Effect of thermal hysteresis on structural changes of water restrained in poly(vinyl alcohol) pseudo-gel. Eur. Polym. J. 1987, 23, 361–365. [Google Scholar] [CrossRef]
- Rogozhin, S.V.; Lozinsky, V.I.; Vainerman, E.S.; Domotenko, L.V.; Mamtsis, A.M.; Ivanova, S.A.; Shtil’man, M.I.; Korshak, V.V. Non-covalent cryostructuration in polymer systems. Dokl. Akad. Nauk SSSR 1984, 278, 129–133. (In Russian) [Google Scholar]
- Lozinsky, V.I.; Domotenko, L.V.; Vainerman, E.S.; Titova, E.F.; Mamtsis, A.M.; Belavtseva, E.M.; Rogozhin, S.V. Study of cryostructurization of polymer systems. VII. Structure formation under freezing of poly(vinyl alcohol) aqueous solutions. Colloid Polym. Sci. 1986, 264, 19–24. [Google Scholar] [CrossRef]
- Altunina, L.K.; Kuvshinov, V.A.; Dolgikh, S.N. Cryogels—A promising material for underground works in permafrost. In Advances in Geological Storage of Carbon Dioxide; Lombardi, S., Altunina, L.K., Beaubien, S.E., Eds.; NATO Science Series IV; Springer: Heidelberg, Germany, 2006; Volume 65, pp. 103–110. ISBN 978-1-4020-4469-4. [Google Scholar]
- Gun’ko, V.M.; Savina, I.N.; Mikhalovsky, S.V. Cryogels: Morphological, structural and adsorption characterization. Adv. Colloid Interface Sci. 2013, 187–188, 1–46. [Google Scholar] [CrossRef]
- Zhang, H.; Zhang, F.; Wu, J. Physically crosslinked hydrogels prepared by freeze-thaw technique. React. Funct. Polym. 2013, 73, 923–928. [Google Scholar] [CrossRef]
- Lozinsky, V.I. A brief history of polymeric cryogels. Adv. Polym. Sci. 2014, 263, 1–48. [Google Scholar] [CrossRef]
- Vasiliev, N.K.; Pronk, A.D.C.; Shatalina, I.N.; Janssen, F.H.M.E.; Houben, R.W.G. A review on the development of reinforced ice for use as a building material in cold regions. Cold Reg. Sci. Technol. 2015, 115, 56–63. [Google Scholar] [CrossRef]
- Teodorescu, M.; Bercea, M.; Morariu, S. Biomaterials of poly(vinyl alcohol) and natural polymers. Polym. Rev. 2018, 58, 247–287. [Google Scholar] [CrossRef]
- Lozinsky, V.I. Cryostructuring of polymeric systems. 55. Retrospective view on the more than 40-years studies performed in the A.N.Nesmeyanov Institute of Organoelement Compounds with respect of the cryostructuring processes in polymeric systems. Gels 2020, 6, 29. [Google Scholar] [CrossRef] [PubMed]
- Omidian, H.; Chowdhury, S.D.; Babanejad, N. Cryogels: Advancing biomaterials for transformative biomedical applications. Pharmaceutics 2023, 15, 1836. [Google Scholar] [CrossRef]
- Okay, O. Cryogelation reactions and cryogels: Principles and challenges. Turk. J. Chem. 2023, 47, 910–926. [Google Scholar] [CrossRef]
- Nambu, M. Rubber-like poly(vinyl alcohol) gel. Kobunshi Ronbunshu 1990, 47, 695–703. (In Japanese) [Google Scholar] [CrossRef]
- Lazzeri, L. Progress in bioartificial polymeric materials. Trends Polym. Sci. 1996, 4, 249–252. [Google Scholar]
- Mori, Y.; Tokura, H.; Yoshikawa, M. Properties of hydrogels synthesized by freezing and thawing aqueous poly(vinyl alcohol) solutions and their applications. J. Mater. Sci. 1997, 32, 491–496. [Google Scholar] [CrossRef]
- Chu, K.C.; Rutt, B.K. Poly(vinyl alcohol) cryogel: An ideal phantom material for MR studies of arterial flow and elasticity. Magn. Reson. Med. 1997, 37, 314–319. [Google Scholar] [CrossRef] [PubMed]
- Alves, M.H.; Jensen, B.E.B.; Smith, A.A.A.; Zelikin, A.N. Poly(vinyl alcohol) physical hydrogels: New vista on a long serving biomaterial. Macromol. Biosci. 2011, 11, 1293–1313. [Google Scholar] [CrossRef] [PubMed]
- Baker, M.I.; Walsh, S.P.; Schwatz, Z.; Boyan, B.D. A review of polyvinyl alcohol and its uses in cartilage and orthopedic applications. J. Biomed. Mater. Res. B 2012, 100, 1451–1457. [Google Scholar] [CrossRef] [PubMed]
- Gajra, B.; Pandya, S.S.; Vidyasagar, G.; Rabari, H.; Dedania, R.R.; Rao, S. Poly(vinyl alcohol) hydrogel and its pharmaceutical and biomedical applications: A review. Int. J. Pharm. Res. 2012, 4, 20–26. [Google Scholar]
- Maiolo, A.S.; Amado, M.N.; Gonzalez, J.S.; Alvarez, V.A. Development and characterization of poly (vinyl alcohol) based hydrogels for potential use as an articular cartilage replacement. Mater. Sci. Eng. C 2012, 32, 1490–1495. [Google Scholar] [CrossRef]
- Wan, W.; Bannerman, A.D.; Yang, L.; Mak, H. Poly(vinyl alcohol) cryogels for biomedical applications. Adv. Polym. Sci. 2014, 263, 283–321. [Google Scholar] [CrossRef]
- Kumar, A.; Han, S.S. PVA-based hydrogels for tissue engineering: A review. Int. J. Polym. Mater. Polym. Biomater. 2017, 66, 159–182. [Google Scholar] [CrossRef]
- Memic, A.; Colombani, T.; Eggermont, L.J.; Rezaeeyazdi, M.; Steingold, J.; Rogers, Z.J.; Navare, K.J.; Mohammed, H.S.; Bencherif, S.A. Latest advances in cryogel technology for biomedical applications. Adv. Ther. 2019, 2, 1800114. [Google Scholar] [CrossRef]
- Rivera-Hernández, G.; Antunes-Ricardo, M.; Martínez-Morales, P.; Sánchez, L. Polyvinyl alcohol based-drug delivery systems for cancer treatment. Int. J. Pharm. 2021, 600, 120478. [Google Scholar] [CrossRef]
- Takamura, A.; Ishii, F.; Hidaka, H. Drug release from poly (vinyl alcohol) gel prepared by freeze-thaw procedure. J. Control. Release 1992, 20, 21–27. [Google Scholar] [CrossRef]
- Peppas, N.A.; Mongia, N.K. Ultrapure poly (vinyl alcohol) hydrogels with mucoadhesive drug delivery characteristics. Eur. J. Pharm. Biopharm. 1997, 43, 51–58. [Google Scholar] [CrossRef]
- Peppas, N.A.; Simmons, R.E.P. Mechanistic analysis of protein delivery from porous poly(vinyl alcohol) systems. J. Drug Deliv. Sci. Technol. 2004, 14, 285–289. [Google Scholar] [CrossRef]
- Lee, M.; Bae, H.; Lee, S.; Nae-oh, C.; Lee, H.; Choi, S.; Hwang, S.; Lee, J.; Nae-oh, C.; Lee, H.; et al. Freezing/thawing processing of PVA in the preparation of structured microspheres for protein drug delivery. Macromol. Res. 2011, 19, 130–136. [Google Scholar] [CrossRef]
- Slasko, J.; Berzina-Cimdina, L.; Kalnins, M. Characterization of cryogenically slightly crosslinked biomedical poly(vinyl alcohol) gels. Proc. Estonian Acad. Sci. 2012, 61, 228–236. [Google Scholar] [CrossRef]
- Solomennyi, A.M. Mathematical substantiation of the technology of creating a pharmaceutical composition in the form of cryogel. Pharmacophore 2021, 12, 98–105. [Google Scholar] [CrossRef]
- Górska, A.; Krupa, A.; Majda, D.; Kulinowski, P.; Kurek, M.; Węglarz, W.P.; Jachowicz, R. Poly(vinyl alcohol) cryogel membranes loaded with resveratrol as potential active wound dressings. AAPS PharmSciTech 2021, 22, 109. [Google Scholar] [CrossRef] [PubMed]
- Durham, P.G.; Kim, J.; Eltz, R.M.; Caskey, C.F.; Dayton, P.A. Polyvinyl alcohol cryogels for acoustic characterization of phase change contrast agents. Ultrasound Med. Biol. 2022, 48, 954–960. [Google Scholar] [CrossRef] [PubMed]
- Akin, A.; Ozmen, M.M. Antimicrobial cryogel dressings towards effective wound healing. Prog. Biomater. 2022, 11, 331–346. [Google Scholar] [CrossRef]
- Hadi, Z.; Ahmadi, E.; Shams-Esfandabadi, N.; Davoodian, N.; Shirazi, A.; Moradian, M. Polyvinyl alcohol addition to freezing extender can improve the post-thaw quality, longevity and in vitro fertility of ram epididymal spermatozoa. Cryobiology 2024, 14, 104853. [Google Scholar] [CrossRef] [PubMed]
- Shiga, T.; Hirose, Y.; Okada, A.; Kurauchi, T. Bending of ionic polymer gel caused by swelling under sinusoidally varying electric field. J. Appl. Polym. Sci. 1993, 47, 113–119. [Google Scholar] [CrossRef]
- Iio, K.; Minoura, N.; Nagura, M. Swelling characteristics of a blend hydrogel made of poly(allylbiguanidino-co-allylamine) and poly(vinyl alcohol). Polymer 1995, 36, 2579–2583. [Google Scholar] [CrossRef]
- Cascone, M.G.; Maltini, S.; Barbani, N.; Laus, M. Effect of chitosan and dextran on the properties of poly(vinyl alcohol) hydrogels. J. Mater. Sci. Mater. Med. 1999, 10, 431–435. [Google Scholar] [CrossRef]
- Gascone, M.G.; Barbani, N.; Maltinti, S.; Lazzari, L. Gellan/poly(vinyl alcohol) hydrogels: Characterization and evaluation as delivery systems. Polym. Int. 2001, 50, 1241–1246. [Google Scholar] [CrossRef]
- Yu, H.; Xu, X.; Chen, X.; Lu, T.; Zhang, P.; Jing, X. Preparation and antibacterial effects of PVA-PVP hydrogels containing silver nanoparticles. J. Appl. Polym. Sci. 2007, 103, 125–133. [Google Scholar] [CrossRef]
- Kim, J.O.; Choi, J.Y.; Park, J.K.; Kim, J.H.; Jin, S.G.; Chang, S.W.; Li, D.X.; Hwang, M.-R.; Woo, J.S.; Kim, J.-A. Development of clindamycin-loaded wound dressing with polyvinyl alcohol and sodium alginate. Biol. Pharm. Bull. 2008, 31, 2277–2282. [Google Scholar] [CrossRef]
- Nešović, K.; Janković, A.; Kojić, V.; Vukašinović-Sekulić, M.; Perić-Grujić, A.; Rhee, K.Y.; Mišković-Stanković, V. Silver/poly (vinyl alcohol)/chitosan/graphene hydrogels—Synthesis, biological and physicochemical properties and silver release kinetics. Compos. B Eng. 2018, 154, 175–185. [Google Scholar] [CrossRef]
- Figueroa-Pizano, M.; Velaz, I.; Penas, F.; Zavala-Rivera, P.; Rosas-Durazo, A.; Maldonado-Arce, A.; Martinez-Barbosa, M. Effect of freeze-thawing conditions for preparation of chitosan-poly (vinyl alcohol) hydrogels and drug release studies. Carbohydr. Polym. 2018, 195, 476–485. [Google Scholar] [CrossRef]
- Ensandoost, R.; Izadi-Vasafi, H.; Adelnia, H. Anti-bacterial activity of chitosan-alginate-poly(vinyl alcohol) hydrogel containing entrapped peppermint essential oil. J. Macromol. Sci. Part B 2021, 61, 225–237. [Google Scholar] [CrossRef]
- Chandika, P.; Kim, M.-S.; Khan, F.; Kim, Y.-M.; Heo, S.-Y.; Oh, G.-W.; Kim, N.G.; Jung, W.-K. Wound healing properties of triple cross-linked poly(vinyl alcohol)/methacrylate kappa-carrageenan/chitooligosaccharide hydrogel. Carbohydr. Polym. 2021, 269, 118272. [Google Scholar] [CrossRef] [PubMed]
- Aderibigbe, B.A. Hybrid-based wound dressing: Combination of synthetic and biopolymers. Polymers 2022, 11, 3806. [Google Scholar] [CrossRef]
- Bercea, M.; Plugariu, I.A.; Dinu, M.V.; Pelin, I.M.; Lupu, A.; Bele, A.; Gradinaru, V.R. Poly(vinyl alcohol)/bovine serum albumin hybrid hydrogels with tunable mechanical properties. Polymers 2023, 15, 4611. [Google Scholar] [CrossRef]
- Jeong, J.-p.; Kim, K.; Kim, J.; Kim, Y.; Jung, S. New polyvinyl alcohol/succinoglycan-based hydrogels for pH-responsive drug delivery. Polymers 2023, 15, 3009. [Google Scholar] [CrossRef]
- Serbezeanu, D.; Iftime, M.M.; Ailiesei, G.-L.; Ipate, A.-M.; Bargan, A.; Vlad-Bubulač, T.; Rîmbu, C.M. Evaluation of poly(vinyl alcohol)–xanthan gum hydrogels loaded with neomycin sulfate as systems for drug delivery. Gels 2023, 9, 655. [Google Scholar] [CrossRef]
- Ding, Z.; Wang, Y.; Chen, F.; Hu, X.; Cheng, W.; Lu, Q.; Kaplan, D.L. Biomimetic vascular grafts with circumferentially and axially oriented microporous structures for native blood vessel regeneration. Adv. Funct. Mater. 2024, 34, 2308888. [Google Scholar] [CrossRef]
- Rîmbu, C.M.; Serbezeanu, D.; Vlad-Bubulač, T.; Suflet, D.M.; Motrescu, I.; Lungoci, C.; Robu, T.; Vrînceanu, N.; Grecu, M.; Cozma, A.P.; et al. Antimicrobial activity of Artemisia dracunculus oil-loaded agarose/poly(vinyl alcohol) hydrogel for bio-applications. Gels 2024, 10, 26. [Google Scholar] [CrossRef] [PubMed]
- Prűsse, U.; Hähnlein, M.; Daum, J.; Vorlop, K.-D. Improving the catalyitic nitrate reduction. Catal. Today 2000, 55, 79–90. [Google Scholar] [CrossRef]
- Hill, B.; Bäck, S.Å.J.; Lepage, M.; Simpson, J.; Healy, B.; Baldock, C. Investigation and analysis of ferrous sulfate polyvinyl alcohol (PVA) gel dosimeter. Phys. Med. Biol. 2002, 47, 4233. [Google Scholar] [CrossRef] [PubMed]
- Galeska, I.; Kim, T.K.; Patil, S.D.; Bhardwaj, U.; Chatttopadhyaya, D.; Papadimitrakopoulos, F.; Burgess, D.J. Controlled release of dexamethasone from PLGA microspheres embedded within polyacid-containing PVA hydrogels. AAPS J. 2005, 7, 22. [Google Scholar] [CrossRef] [PubMed]
- Pan, Y.; Xiong, D.; Chen, X. Mechanical properties of nanohydroxyapatite reinforced poly(vinyl alcohol) gel composites as biomaterial. J. Mater. Sci. 2007, 42, 5129–5134. [Google Scholar] [CrossRef] [PubMed]
- Kokabi, M.; Sirousazar, M.; Hassan, Z.M. PVA-clay nanocomposite hydrogels for wound dressing. Eur. Polym. J. 2007, 43, 773–781. [Google Scholar] [CrossRef]
- Zelis, P.A.; Muraca, D.; Gonzalez, J.S.; Pasquevich, G.A.; Alvarez, V.A.; Pirota, K.R.; Sanchez, F.H. Magnetic properties study of iron-oxide nanoparticles/PVA ferrogels with potential biomedical applications. J. Nanopart. Res. 2013, 15, 1613. [Google Scholar] [CrossRef]
- Timofejeva, A.; D’Este, M.; Loca, D. Calcium phosphate/polyvinyl alcohol composite hydrogels: A review on the freeze-thaw synthesis approach and applications in regenerative medicine. Eur. Polym. J. 2017, 95, 547–565. [Google Scholar] [CrossRef]
- Tamer, T.M.; Sabet, M.M.; Omer, A.M.; Abbas, E.; Eid, A.I.; Mohy-Eldin, M.S.; Hassan, M.A. Hemostatic and antibacterial PVA/kaolin composite sponges loaded with penicillin-streptomycin for wound dressing applications. Sci. Rep. 2021, 11, 3428. [Google Scholar] [CrossRef]
- Tamahkar, E. Bacterial cellulose/poly vinyl alcohol based wound dressings with sustained antibiotic delivery. Chem. Pap. 2021, 75, 3979–3987. [Google Scholar] [CrossRef]
- Otulakowski, L.; Klama-Baryła, A.; Celny, A.; Kasprow, M.; Hercog, A.; Godzierz, M.; Sitkowska, A.; Kadłubowski, S.; Jaworska, M.; Chmielik, E.; et al. Laminar biomaterial composite of PVA cryogel with amnion as potential wound dressing. Polymers 2023, 15, 2955. [Google Scholar] [CrossRef] [PubMed]
- Shaikhaliev, A.I.; Korshakov, E.V.; Kolosova, O.Y.; Krasnov, M.S.; Lozinsky, V.I. Temporary Implant for the Patients with Infected Defects in the Maxillofacial Region and a Method for Treating Them Using Such an Implant. Russian Patent 2,729,929, 13 August 2020. [Google Scholar]
- Kolosova, O.Y.; Shaikhaliev, A.I.; Krasnov, M.S.; Bondar, I.M.; Sidorskii, E.V.; Sorokina, E.V.; Lozinsky, V.I. Cryostructuring of polymeric systems. 64. Preparation and properties of poly(vinyl alcohol)-based cryogels loaded with antimicrobial drugs and assessment of the potential of such gel materials to perform as the gel implants for treatment of infected wounds. Gels 2023, 9, 113. [Google Scholar] [CrossRef]
- Vidovič, S.; Stojkovska, J.; Stevanovič, M.; Balanc, B.; Vukasinovič-Sekulič, M.; Marinkovič, A.; Obradovič, B. Effects of poly(vinyl alcohol) blending with Ag/alginate solutions to form nanocomposite fibres for potential use as antibacterial wound dressings. R. Soc. Open Sci. 2021, 9, 211517. [Google Scholar] [CrossRef] [PubMed]
- Xiong, S.; Li, R.; Ye, S.; Ni, P.; Shan, J.; Yuan, T.; Liang, J.; Fan, Y.; Zhang, X. Vanillin enhances the antibacterial and antioxidant properties of polyvinyl alcohol-chitosan hydrogel dressings. Int. J. Biol. Macromol. 2022, 220, 109–116. [Google Scholar] [CrossRef] [PubMed]
- Ningrum, D.R.; Halif, W.; Mardhian, D.F.; Asri, L.A.T.W. In vitro biocompatibility of hydrogel polyvinyl alcohol/moringa oleifera leaf extract/graphene oxide for wound dressing. Polymers 2023, 15, 468. [Google Scholar] [CrossRef]
- Shaheen, S.M.; Ukai, K.; Dai, L.X.; Yamaura, K. Properties of hydrogels of atactic poly(vinyl alcohol)/NaCl/H2O system and their application to drug release. Polym. Int. 2002, 51, 1390–1397. [Google Scholar] [CrossRef]
- Patachia, S.; Valente, A.J.M.; Baciu, C. Effect of non-associated electrolyte solutions on the behavior of poly(vinyl alcohol)-based hydrogels. Eur. Polym. J. 2007, 43, 460–467. [Google Scholar] [CrossRef]
- Patachia, S.; Florea, C.; Friedrich, C.; Thomann, Y. Tailoring of poly(vinyl alcohol) cryogels properties by salts addition. Express Polym. Lett. 2009, 3, 320–331. [Google Scholar] [CrossRef]
- Lozinsky, V.I.; Sakhno, N.G.; Damshkaln, L.G.; Bakeeva, I.V.; Zubov, V.P.; Kurochkin, I.N.; Kurochkin, I.I. Study of cryostructuring of polymer systems. 31. Influence of the additives of alkaline metals chlorides on physicochemical properties and morphology of poly(vinyl alcohol) cryogels. Colloid J. 2011, 73, 234–243. [Google Scholar] [CrossRef]
- Branco, A.C.; Oliveira, A.; Monteiro, I.; Nolasco, P.; Silva, D.C.; Figueiredo-Pina, C.G.; Colaço, R.; Serro, A.P. PVA-based hydrogels loaded with diclofenac for cartilage replacement. Gels 2022, 8, 143. [Google Scholar] [CrossRef]
- Kolosova, O.Y.; Kurochkin, I.N.; Kurochkin, I.I.; Lozinsky, V.I. Cryostructuring of polymeric systems. 48. Influence of organic non-ionic and ionic chaotropes or kosmotropes on the cryotropic gel-formation of aqueous poly(vinyl alcohol) solutions, as well as on the properties and microstructure of the resultant cryogels. Eur. Polym. J. 2018, 102, 169–177. [Google Scholar] [CrossRef]
- Masuda, K.; Horii, F. CP/MAS 13C NMR analyses of the chain conformation and hydrogen bonding for frozen poly(vinyl alcohol) solutions. Macromolecules 1998, 31, 5810–5817. [Google Scholar] [CrossRef]
- Kobayashi, M.; Ando, I.; Ishii, T.; Amiya, S. Structural and dynamical studies of poly(vinyl alcohol) gels by high-resolution solid-state 13C NMR spectroscopy. J. Mol. Struct. 1998, 440, 155–164. [Google Scholar] [CrossRef]
- Lai, S.; Casu, M.; Saba, G.; Lai, A.; Husu, I.; Masci, G.; Crescenzi, V. Solid-state 13C NMR study of poly(vinyl alcohol) gels. Solid-State Nucl. Magn. Res. 2002, 21, 187–196. [Google Scholar] [CrossRef] [PubMed]
- Kolosova, O.Y.; Karelina, P.A.; Vasil’ev, V.G.; Grinberg, V.Y.; Kurochkin, I.I.; Kurochkin, I.N.; Lozinsky, V.I. Cryostructuring of polymeric systems. 58. Influence of the H2N-(CH2)n-COOH–type amino acid additives on formation, properties, microstructure and drug release behavior of poly(vinyl alcohol) cryogels. React. Funct. Polym. 2021, 167, 105010. [Google Scholar] [CrossRef]
- Lozinsky, V.I.; Damshkaln, L.G.; Kurochkin, I.N.; Kurochkin, I.I. Study of cryostructuration of polymer systems. 25. Influence of surfactants on the properties and structure of gas-filled (foamed) poly(vinyl alcohol) cryogels. Colloid J. 2005, 67, 589–601. [Google Scholar] [CrossRef]
- Euti, E.M.; Wolfel, A.; Piccio, M.L.; Romero, M.R.; Martinelli, M.; Minari, R.J.; Igarzabal, C.I.A. Controlled thermoreversible formation of supramolecular hydrogels based on poly(vinyl alcohol) and natural phenolic compounds. Macromol. Rap. Commun. 2019, 40, 1900217. [Google Scholar] [CrossRef] [PubMed]
- Lucue, G.C.; Piccio, M.L.; Martins, A.P.S.; Dominguez-Alfaro, A.; Tomé, L.C.; Mecerreyes, D.; Minari, R.J. Elastic and thermoreversible iongels by supramolecular PVA/phenol interactions. Macromol. Biosci. 2020, 20, 2000119. [Google Scholar] [CrossRef]
- Ni, Q.; Ye, W.; Du, M.; Shan, G.; Song, Y.; Zheng, Q. Effect of hydrogen bonding on dynamic rheological behavior of PVA aqueous solution. Gels 2022, 8, 518. [Google Scholar] [CrossRef]
- Korzybski, T.; Kowszyk-Gindifer, Z.; Kuryłowicz, W. Antibiotics: Origin, Nature and Properties; Pergamon Press: Oxford, UK, 1967; 1651p. [Google Scholar]
- Kowalczyk, M.; Golonko, A.; Świsłocka, R.; Kalinowska, M.; Parcheta, M.; Swiergiel, A.; Lewandowski, W. Drug design strategies for the treatment of viral disease: Plant phenolic compounds and their derivatives. Front. Pharmacol. 2021, 12, 709104. [Google Scholar] [CrossRef]
- Sun, W.; Shahrajabian, M.H. Therapeutic potential of phenolic compounds in medicinal Plants—Natural health products for human health. Molecules 2023, 28, 1845. [Google Scholar] [CrossRef] [PubMed]
- Soto, M.L.; Falqué, E.; Domínguez, H. Relevance of natural phenolics from grape and derivative products in the formulation of cosmetics. Cosmetics 2015, 2, 259–276. [Google Scholar] [CrossRef]
- Przybylska-Balcerek, A.; Stuper-Szablewska, K. Phenolic acids used in the cosmetics industry as natural antioxidants. Eur. J. Med. Technol. 2019, 4, 24–32. [Google Scholar]
- Lozinsky, V.I.; Damshkaln, L.G.; Shaskol’skii, B.L.; Babushkina, T.A.; Kurochkin, I.N.; Kurochkin, I.I. Study of cryostructuring of polymer systems. 27. Physicochemical properties of poly(vinyl alcohol) cryogels and features of their macroporous morphology. Colloid J. 2007, 69, 747–764. [Google Scholar] [CrossRef]
- Lozinsky, V.I.; Damshkaln, L.G.; Kurochkin, I.N.; Kurochkin, I.I. Study of cryostructuring of polymer systems. 33. Effect of rate of chilling aqueous poly(vinyl alcohol) solutions during their freezing on physicochemical properties and porous structure of resulting cryogels. Colloid J. 2012, 74, 319–327. [Google Scholar] [CrossRef]
- Lozinsky, V.I.; Okay, O. Basic principles of cryotropic gelation. Adv. Polym. Sci. 2014, 263, 49–102. [Google Scholar] [CrossRef]
- Sergeev, G.B.; Batyuk, V.A. Reactions in frozen multicomponent systems. Russ. Chem. Revs. 1976, 45, 391–408. [Google Scholar] [CrossRef]
- Haynes, W.M.; Lide, D.R.; Bruno, T.J. (Eds.) CRC Handbook of Chemistry and Physics: A Ready-Reference Book of Chemical and Physical Data, 97th ed.; CRS Press: Boca Raton, FL, USA, 2016; ISBN 978-1-4987-5428-6. [Google Scholar]
- Shiekh, P.A.; Andrabia, S.M.; Singh, A.; Majumder, S.; Kumar, A. Designing cryogels through cryostructuring of polymeric matrices for biomedical applications. Eur. Polym. J. 2021, 144, 110234. [Google Scholar] [CrossRef]
- Yokoyama, F.; Masada, I.; Shimamura, K.; Ikawa, T.; Monobe, K. Morphology and structure of highly elastic poly(vinyl alcohol) hydrogel prepared by repeated freezing-and-melting. Colloid Polym. Sci. 1986, 264, 595–601. [Google Scholar] [CrossRef]
- Yamaura, K.; Tanigami, T.; Hayashi, N.; Kosuda, N.; Okuda, S.; Takemura, Y.; Itoh, M.; Matsuzawa, S. Preparation of high modulus poly(vinyl alcohol) by drawing. J. Appl. Polym. Sci. 1990, 40, 905–916. [Google Scholar] [CrossRef]
- Stammen, J.A.; Williams, S.; Ku, D.K.; Guldberg, R.E. Mechanical properties of a novel PVA hydrogel in shear and unconfined compression. Biomaterials 2001, 22, 799–806. [Google Scholar] [CrossRef] [PubMed]
- Gupta, S.; Goswami, S.; Sinha, A. A combined effect of freeze-thaw cycles and polymer concentration on the structure and mechanical properties of transparent PVA gels. Biomed. Mater. 2012, 7, 015006. [Google Scholar] [CrossRef]
- Nishinari, K.; Watase, M.; Tanaka, F. Structure of junction zones in poly(vinyl alcohol) gels by rheological and thermal studies. J. Chim. Phys. 1996, 93, 880–886. [Google Scholar] [CrossRef]
- Hatakeyema, T.; Uno, J.; Yamada, C.; Kishi, A.; Hatakeyama, H. Gel–sol transition of poly(vinyl alcohol) hydrogels formed by freezing and thawing. Thermochim. Acta 2005, 431, 144–148. [Google Scholar] [CrossRef]
- Pimentel, G.; McClellan, A.I. The Hydrogen Bond; W.H.Freeman & Co.: San Francisco, CA, USA, 1960; 475p, ISBN 978-0716701132. [Google Scholar]
- Lozinsky, V.I.; Zubov, A.L.; Titova, E.F. Swelling behavior of poly(vinyl alcohol) cryogels employed as matrices for cell immobilization. Enzym. Microb. Technol. 1996, 18, 561–569. [Google Scholar] [CrossRef]
- Lozinsky, V.I.; Zubov, A.L.; Savina, I.N.; Plieva, F.M. Study of cryostructuration of polymer systems. XIV. Poly(vinyl alcohol) cryogels: Apparent yield of the freeze-thaw-induced gelation of concentrated aqueous solutions of the polymer. J. Appl. Polym. Sci. 2000, 77, 1822–1831. [Google Scholar] [CrossRef]
- Trieu, H.H.; Qutubuddin, S. Poly(vinyl alcohol) hydrogels. 2. Effects of processing parameters on structure and properties. Polymer 1995, 36, 2531–2539. [Google Scholar] [CrossRef]
- Willcox, P.J.; Howie, D.W.; Schmidt-Rohr, K.; Hoagland, D.A.; Gido, S.P.; Pudjijanto, S.; Kleiner, W.; Venkatraman, S. Microstructure of poly(vinyl alcohol) hydrogels produced by freeze/thaw cycling. J. Polym. Sci. B Polym. Phys. 1999, 37, 3438–3454. [Google Scholar] [CrossRef]
- Kurochkin, I.I.; Kurochkin, I.N.; Kolosova, O.Y.; Lozinsky, V.I. Cryostructuring of polymeric systems. 56. Application of deep neural networks for the classification of structural features peculiar to macroporous poly(vinyl alcohol) cryogels prepared without and with the additives of chaotropes or kosmotropes. Molecules 2020, 25, 4480. [Google Scholar] [CrossRef] [PubMed]
- Adelnia, H.; Ensandoost, R.; Moonshi, S.S.; Gavgani, J.N.; Vasafi, E.I.; Ta, H.T. Freeze/thawed polyvinyl alcohol hydrogels: Present, past and future. Eur. Polym. J. 2022, 164, 110974. [Google Scholar] [CrossRef]
- Fergg, F.; Keil, F.; Quader, H. Investigations of the microscopic structure of poly(vinyl alcohol) hydrogels by confocal laser scanning microscopy. Colloid Polym. Sci. 2001, 279, 61–67. [Google Scholar] [CrossRef]
- Klivenko, A.N.; Mussabaeva, B.K.; Gaisina, B.S.; Sabitova, A.N. Biocompatible cryogels: Preparation and application. Bull. Univ. Karaganda—Chem. 2021, 103, 4–20. [Google Scholar] [CrossRef]
- Weibull, W. A statistical distribution function of wide applicability. J. Appl. Mech. 1951, 18, 293–297. [Google Scholar] [CrossRef]
- Papadopoulou, V.; Kosmidis, K.; Vlachou, M.; Macheras, P. On the use of the Weibull function for the discernment of drug release mechanisms. Int. J. Pharm. 2006, 309, 44–50. [Google Scholar] [CrossRef]
- Peppas, N.A.; Narasimhan, B. Mathematical models in drug delivery: How modeling has shaped the way we design new drug delivery systems. J. Control. Release 2014, 190, 75–81. [Google Scholar] [CrossRef]
- Kosmidis, K.; Argyrakis, P.; Macheras, P. A reappraisal of drug release laws using Monte Carlo simulations: The prevalence of the Weibull function. Pharm. Res. 2003, 20, 988–995. [Google Scholar] [CrossRef] [PubMed]
- Bonev, B.; Hooper, J.; Parisot, J. Principles of assessing bacterial susceptibility to antibiotics using the agar diffusion method. J. Antimicrob. Chemother. 2008, 61, 1295–1301. [Google Scholar] [CrossRef] [PubMed]
- Kocaçalışkan, I.; Talan, I.; Terzi, I. Antimicrobial activity of catechol and pyrogallol as allelochemicals. Z. Naturforsch. 2006, 61, 639–642. [Google Scholar] [CrossRef] [PubMed]
- Ma, C.; He, N.; Zhao, Y.; Xia, D.; Wei, J.; Kang, W. Antimicrobial mechanism of hydroquinone. Appl. Biochem. Biotechnol. 2019, 189, 1291–1303. [Google Scholar] [CrossRef] [PubMed]
- Ariga, O.; Kubo, T.; Sano, Y. Effective diffusion of glucose in PVA hydrogel. J. Ferment. Bioeng. 1994, 78, 200–201. [Google Scholar] [CrossRef]
- Gordon, M.J.; Chu, K.C.; Margaritis, A.; Martin, A.J.; Ethier, C.R.; Rutt, B.K. Measurement of Gd-DTPA diffusion through PVA hydrogel using a novel magnetic resonance imaging method. Biotechnol. Bioeng. 1999, 65, 459–467. [Google Scholar] [CrossRef]
- Jiang, S.; Liu, S.; Feng, W. PVA hydrogel properties for biomedical application. J. Mech. Behav. Biomed. Mater. 2011, 4, 1228–1233. [Google Scholar] [CrossRef] [PubMed]
- Martinez, Y.N.; Piñuel, L.; Castro, G.R.; Breccia, J.D. Polyvinyl alcohol–pectin cryogel films for controlled release of enrofloxacin. Appl. Biochem. Biotechnol. 2012, 167, 1421–1429. [Google Scholar] [CrossRef]
- Lotfipour, F.; Alami-Milani, M.; Salatin, M.; Hadavi, A.; Jelvehgari, M. Freeze-thaw-induced cross-linked PVA/chitosan for oxytetracycline-loaded wound dressing: The experimental design and optimization. Res. Pharm. Sci. 2019, 14, 175–189. [Google Scholar] [CrossRef]
- Azri, Q.A.; Jahari, F.I.M.; Hussain, F.S.J.; Zulkifli, F.H. Synthesis and characterization of bromelain enzyme/poly(vinyl alcohol) as potential bone scaffold. Curr. Sci. Technol. 2022, 2, 67–73. [Google Scholar] [CrossRef]
- Michurov, D.A.; Makhina, T.K.; Siracusa, V.; Bonartsev, A.P.; Lozinsky, V.I.; Iordanskii, A.L. Cryo-structuring of polymeric systems. 60. Poly(vinyl alcohol)-based cryogels loaded with the poly(3-hydroxybutyrate) microbeads and the evaluation of such composites as the delivery vehicles for simvastatin. Polymers 2022, 14, 2196. [Google Scholar] [CrossRef] [PubMed]
- Rosciardi, V.; Bandelli, D.; Bassu, G.; Casu, I.; Baglioni, P. Highly biovidal poly(vinyl alcohol)-hydantoin/starch hybrid gels: A “Trojan Horse” for Bacillus subtilis. J. Colloid Interface Sci. 2024, 657, 788–798. [Google Scholar] [CrossRef] [PubMed]

| SEM Image in Figure 6 | Phenolic Additive in the “Primary” Cryogel | Average Pore Size in the “Secondary” Cryogel (μm) |
|---|---|---|
| (a) | Pyrocatechol | 1.70 ± 0.24 |
| (b) | Resorcinol | 2.18 ± 0.30 |
| (c) | Hydroquinone | 2.77 ± 0.35 |
| (d) | Phenol | 4.02 ± 0.52 |
| (e) | None | 2.09 ± 0.27 |
| Phenolic Additive in the PVA Cryogel | Microorganism | GIZ (mm) after Incubation for | |
|---|---|---|---|
| 24 h | 48 h | ||
| Pyrocatechol | Staphylococcus aureus | 30 ± 1 | 32 ± 2 |
| Resorcinol | 64 ± 3 | 65 ± 3 | |
| Hydroquinone | 26 ± 1 | 28 ± 2 | |
| Phenol | 45 ± 2 | 48 ± 3 | |
| Pyrocatechol | Escherichia coli | - | - |
| Resorcinol | 42 ± 3 | 54 ± 3 | |
| Hydroquinone | - | - | |
| Phenol | 39 ± 2 | 42 ± 2 | |
Disclaimer/Publisher’s Note: The statements, opinions and data contained in all publications are solely those of the individual author(s) and contributor(s) and not of MDPI and/or the editor(s). MDPI and/or the editor(s) disclaim responsibility for any injury to people or property resulting from any ideas, methods, instructions or products referred to in the content. |
© 2024 by the authors. Licensee MDPI, Basel, Switzerland. This article is an open access article distributed under the terms and conditions of the Creative Commons Attribution (CC BY) license (https://creativecommons.org/licenses/by/4.0/).
Share and Cite
Kolosova, O.Y.; Vasil’ev, V.G.; Novikov, I.A.; Sorokina, E.V.; Lozinsky, V.I. Cryostructuring of Polymeric Systems: 67 Properties and Microstructure of Poly(Vinyl Alcohol) Cryogels Formed in the Presence of Phenol or Bis-Phenols Introduced into the Aqueous Polymeric Solutions Prior to Their Freeze–Thaw Processing. Polymers 2024, 16, 675. https://doi.org/10.3390/polym16050675
Kolosova OY, Vasil’ev VG, Novikov IA, Sorokina EV, Lozinsky VI. Cryostructuring of Polymeric Systems: 67 Properties and Microstructure of Poly(Vinyl Alcohol) Cryogels Formed in the Presence of Phenol or Bis-Phenols Introduced into the Aqueous Polymeric Solutions Prior to Their Freeze–Thaw Processing. Polymers. 2024; 16(5):675. https://doi.org/10.3390/polym16050675
Chicago/Turabian StyleKolosova, Olga Yu., Viktor G. Vasil’ev, Ivan A. Novikov, Elena V. Sorokina, and Vladimir I. Lozinsky. 2024. "Cryostructuring of Polymeric Systems: 67 Properties and Microstructure of Poly(Vinyl Alcohol) Cryogels Formed in the Presence of Phenol or Bis-Phenols Introduced into the Aqueous Polymeric Solutions Prior to Their Freeze–Thaw Processing" Polymers 16, no. 5: 675. https://doi.org/10.3390/polym16050675
APA StyleKolosova, O. Y., Vasil’ev, V. G., Novikov, I. A., Sorokina, E. V., & Lozinsky, V. I. (2024). Cryostructuring of Polymeric Systems: 67 Properties and Microstructure of Poly(Vinyl Alcohol) Cryogels Formed in the Presence of Phenol or Bis-Phenols Introduced into the Aqueous Polymeric Solutions Prior to Their Freeze–Thaw Processing. Polymers, 16(5), 675. https://doi.org/10.3390/polym16050675








